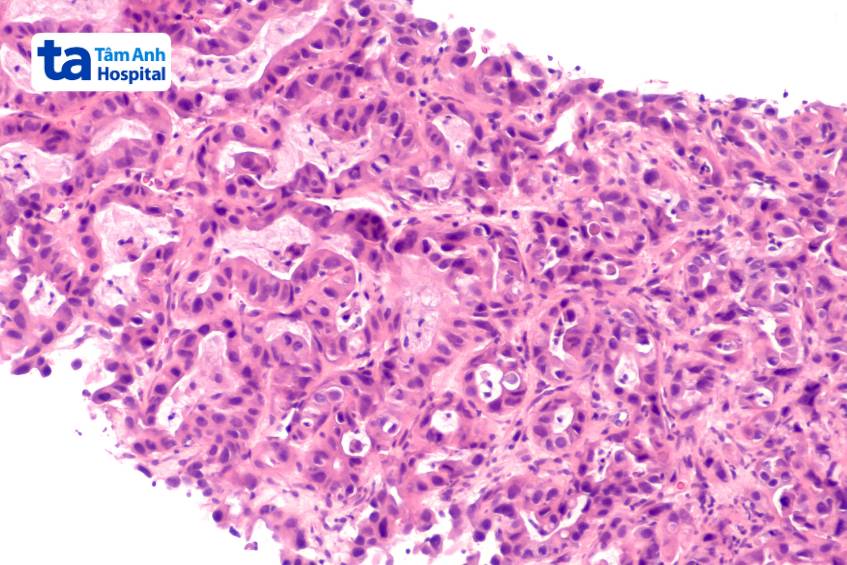
kỹ thuật siêu âm sinh thiết gan

Sinh thiết gan dưới hướng dẫn siêu âm được xem là tiêu chuẩn vàng trong việc đánh giá một số tổn thương gan thường gặp. Quy trình thực hiện nhanh, độ chính xác cao và hiếm khi gây ra biến chứng nghiêm trọng.

Sinh thiết gan dưới hướng dẫn siêu âm là thủ thuật giúp chẩn đoán các tình trạng bất thường ở gan. Trong quá trình thực hiện, bác sĩ sẽ lấy một mẫu mô gan nhỏ và mang đi kiểm tra dưới kính hiển vi. Thông qua kết quả, bác sĩ có thể đánh giá được sức khỏe của gan, nguyên nhân gan bị tổn thương cũng mức độ nghiêm trọng mà người bệnh gan đang gặp phải. Phương pháp sinh thiết gan phổ biến nhất là sinh thiết qua da. Thời gian nằm viện 2 ngày, ngày 1 làm thủ tục xét nghiệm đông máu và thực hiện thủ thuật, bệnh nhân có thể xuất viện vào ngày 2 nếu bệnh ổn.

Các đối tượng chỉ định và chống chỉ định sinh thiết gan dưới hướng dẫn siêu âm được khuyến cáo như sau:
Phương pháp này thường được chỉ định cho các trường hợp sau đây:
Trường hợp chống chỉ định sinh thiết gan dưới hướng dẫn siêu âm bao gồm:
Quy trình sinh thiết gan dưới hướng dẫn siêu âm diễn ra như sau:(1)
Để đảm bảo kết quả sinh thiết gan chính xác, trước khi tiến hành thực hiện, người bệnh cần có sự chuẩn bị kỹ lưỡng theo chỉ định của bác sĩ:
Vào ngày thực hiện thủ thuật bác sĩ sẽ giải thích quy trình, cách thức sinh thiết và các rủi ro liên quan. Sau đó, bệnh nhân ký đồng ý vào các giấy tờ cần thiết trước khi tiến hành.
Bệnh nhân sẽ được đưa đến khu vực tiền phẫu, mang máy đo huyết áp, nhịp tim và độ bão hòa oxy nhằm theo dõi sinh hiệu trong quá trình can thiệp.
Bác sĩ sẽ thực hiện đánh giá trước khi làm thủ thuật, sau đó tiến hành truyền thuốc kháng sinh dự phòng, an thần, thuốc giảm đau trước khi làm thủ thuật. Lúc này, do tác dụng của thuốc, người bệnh có thể cảm thấy buồn ngủ. Các bước tiến hành tiếp theo như sau:
Toàn bộ quy trình sinh thiết kéo dài khoảng 30 phút. Sau khi lấy mẫu, vết thương sẽ được cầm máu và băng lại tại chỗ. Người bệnh được hướng dẫn nằm nghiêng về bên can thiệp trong vòng 2 giờ và ấn chặt vào vị trí can thiệp để ngăn máu chảy. Sau 2 giờ, bệnh nhân có thể ngồi dậy và ăn uống. Bác sĩ có thể chỉ định người bệnh ở phòng hồi sức trong một thời gian để theo dõi.
Sau khi sinh thiết gan, bệnh nhân có thể về nhà vào ngày hôm sau. Kết quả mô có thể có sau vài ngày. Người bệnh lưu ý không tự ý lái xe về nhà sau khi làm sinh thiết, cần có người hỗ trợ trong vòng 24 giờ, tránh vận động. Ngoài ra, bệnh nhân không được dùng aspirin hoặc thuốc chống viêm như ibuprofen trong vòng 3 ngày sau khi sinh thiết để đảm bảo an toàn sức khỏe. Trong vòng 1 tuần đầu sau sinh thiết, người bệnh tuyệt đối không mang vác nặng.(2)
Trước khi sinh thiết, bác sĩ sẽ trao đổi với bệnh nhân về những rủi ro, biến chứng có thể xảy ra, bao gồm:
Biến chứng nghiêm trọng do sinh thiết gan là rất hiếm, nguy cơ tử vong chỉ khoảng 1/10.000. Nếu triệu chứng sốt, đau ngày càng tiến triển nặng hơn hoặc chảy máu không ngừng ở vị trí vết thương, người bệnh cần đi khám ngay. Trong quá trình sinh thiết, rủi ro kim đâm vào các cấu trúc khác trong bụng rất hiếm nhờ được hướng dẫn bằng siêu âm.

Dưới đây là phần giải đáp một số thắc mắc thường gặp liên quan đến phương pháp sinh thiết gan dưới hướng dẫn siêu âm:
Người bệnh có thể cảm thấy hơi khó chịu trong quá trình sinh thiết gan. Triệu chứng khó chịu tại vị trí sinh thiết có thể kéo dài trong vòng 24 – 48 giờ đầu sau khi thực hiện thủ thuật. Trong một số trường hợp, bác sĩ có thể kê thuốc giảm đau.
Mặc dù sinh thiết gan hiện đang là tiêu chuẩn vàng trong chẩn đoán gan nhiễm mỡ không do rượu nhưng vẫn tồn tại tỷ lệ rất nhỏ biến chứng. Cụ thể, tỷ lệ đau được báo cáo là 20%, tăng lên 84% nếu tính cả cảm giác khó chịu nhẹ. Tỷ lệ biến chứng nghiêm trọng và tử vong được báo cáo lần lượt là 0,3% – 0,57% và 0,01%. Để giảm biến chứng, bác sĩ thực hiện sinh thiết đòi hỏi phải có nhiều kinh nghiệm, đồng thời kết hợp sử dụng kim sinh thiết loại hút.
Sinh thiết gan qua da sử dụng hướng dẫn siêu âm là phương pháp chẩn đoán chính xác trong đánh giá mô bệnh học. Đối với chẩn đoán gan nhiễm mỡ do rượu, phương pháp này còn được coi là tiêu chuẩn vàng.
Chi phí sinh thiết gan dưới hướng dẫn siêu âm phụ thuộc vào từng trường hợp cụ thể. Chẳng hạn như, tình trạng cần chẩn đoán, kỹ thuật thực hiện, các phương án điều trị đi kèm… Người bệnh có nhu cầu thăm khám và tư vấn sinh thiết gan, vui lòng liên hệ tổng đài tư vấn của Hệ thống Bệnh viện Đa Khoa Tâm Anh để được hỗ trợ chi tiết.
Nếu người bệnh đang phân vân khi lựa chọn đơn vị sinh thiết gan dưới hướng dẫn siêu âm uy tín, Trung tâm Nội soi và Phẫu thuật Nội soi Tiêu hóa, Hệ thống Bệnh viện Đa khoa Tâm Anh là lựa chọn hàng đầu nên ưu tiên. Đây là địa chỉ đáng tin cậy của nhiều bệnh nhân trong việc thăm khám, chẩn đoán và điều trị các bệnh lý đường tiêu hóa, bao gồm kỹ thuật sinh thiết gan dưới hướng dẫn siêu âm.
Bệnh viện quy tụ đội ngũ bác sĩ Nội tiêu hóa – Ngoại tiêu hóa – Gan, Mật, Tụy – Nội soi tiêu hóa – Hậu môn trực tràng có trình độ chuyên môn cao, giàu kinh nghiệm trong chẩn đoán điều trị, kết hợp với sự hỗ trợ đắc lực từ hệ thống trang thiết bị máy móc hiện đại, tiên tiến, được nhập khẩu từ nước ngoài, đảm bảo chẩn đoán, điều trị đạt hiệu quả cao. .
Để đặt lịch thăm khám, điều trị bệnh tại Hệ thống Bệnh viện Đa khoa Tâm Anh, Quý khách vui lòng liên hệ:
HỆ THỐNG BỆNH VIỆN ĐA KHOA TÂM ANH
Trên đây là tổng hợp tất cả các thông tin cơ bản về phương pháp sinh thiết gan dưới hướng dẫn siêu âm. Hy vọng thông qua những chia sẻ này, bạn đã có thêm nhiều cập nhật hữu ích trong vấn đề chăm sóc sức khỏe, chủ động thăm khám định kỳ để được chẩn đoán và chữa trị kịp thời.